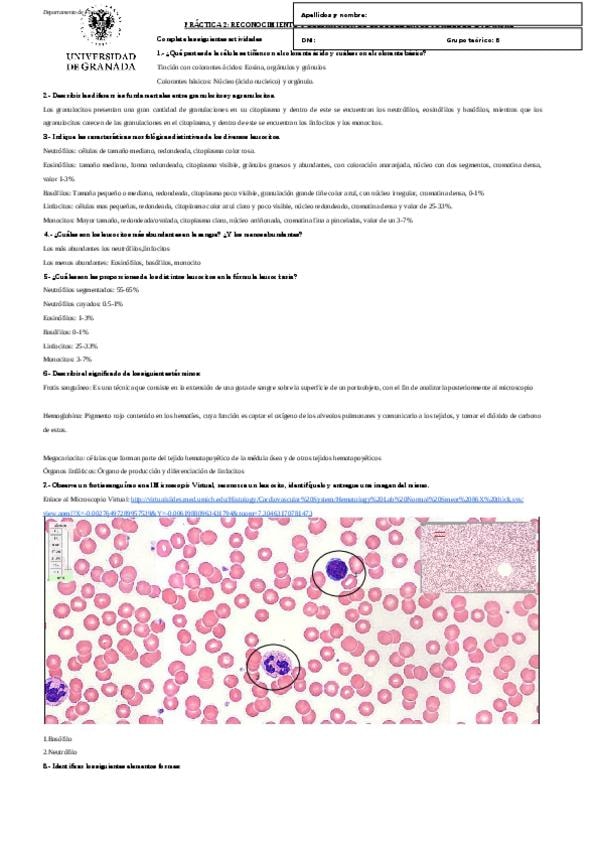

@Paula_472804
49 Publicaciones
694 Interacciones
0 Seguidores
0 Siguiendo
Lista de publicaciones de Paula_472804
apuntes
-
Trabajo intervencion
He publicado nuevos apuntes de 3º Intervención Docente en la Enseñanza de la Activ Física y el Deporte: Trabajo intervencion
He publicado nuevos apuntes de 4º EVALUACIÓN Y CONTROL DEL ENTRENAMIENTO DEPORTIVO: Supuestos.docx
apuntes
-
Practicas
He publicado nuevos apuntes de 2º Fisiología Humana: Practicas
He publicado nuevos apuntes de 2º Sociología del Deporte: BUSQUEDA-DOCUMENTADA-1.pdf
He publicado nuevos trabajos de 1º Anatomía funcional del aparato locomotor: dossier.docx
He publicado nuevos apuntes de 1º Análisis Comportamental y Desarrollo Motor de la Actividad Física: Paula-Garcia.docx
He publicado nuevos trabajos de 1º Análisis Comportamental y Desarrollo Motor de la Actividad Física: Formulario-de-informe-Clases-de-discusion.docx
apuntes
-
Libro nicolas
He publicado nuevos apuntes de 1º FUNDAMENTOS DE HABILIDADES MOTRICES: Libro nicolas
trabajos
-
Trabajo habilidades
He publicado nuevos trabajos de 1º FUNDAMENTOS DE HABILIDADES MOTRICES: Trabajo habilidades
trabajos
-
trabajos autonomos
He publicado nuevos trabajos de 4º Apuntes Variados: trabajos autonomos
He publicado nuevos trabajos de 1º Historia del Deporte: El-escritor-Ngugi-wa-Thiong.docx
He publicado nuevos trabajos de 1º Historia del Deporte: From-Hooligans-to-Heroes-and-from.pptx
He publicado nuevos trabajos de 1º Anatomía funcional del aparato locomotor: Anatomia-dossier.docx
trabajos
-
Salto de longitud:batida
He publicado nuevos trabajos de 4º Apuntes Variados: Salto de longitud:batida
trabajos
-
Trabajos autonomos
He publicado nuevos trabajos de 4º Apuntes Variados: Trabajos autonomos
He publicado nuevos trabajos de 1º Historia del Deporte: de heroes a gamberros.docx
He publicado nuevos trabajos de 4º Apuntes Variados: sesion familiarizacion.pdf